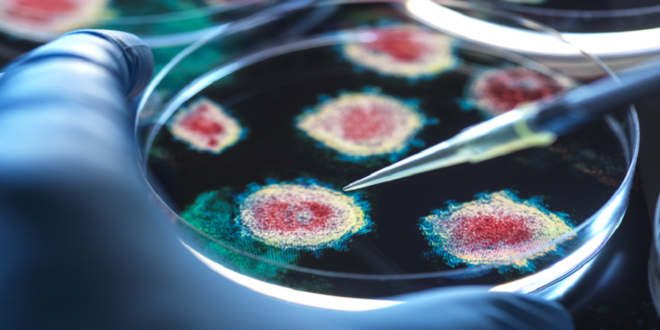

منبر العراق الحر : يواصل خبراء الصحة مراقبة تحورات فيروس H5N1، الذي يُعرف بإنفلونزا الطيور، بعد أن أصاب أكثر من 66 شخصا في الولايات المتحدة، ما يثير القلق بشأن إمكانية تحوره ليتحول إلى تهديد عالمي.
ومع عودة الحياة إلى طبيعتها في العديد من دول العالم بعد سنوات من الإجراءات الصارمة جراء جائحة “كوفيد-19″، يشعر الكثيرون أن هذه الأزمة أصبحت مجرد ذكرى بعيدة. إلا أن خبراء الأمراض المعدية لا يزالون في حالة تأهب، حيث يتابعون تطورات الفيروسات والطفرات الجديدة التي قد تشكل تهديدات صحية.
وما يزال فيروس H5N1 يشكل تهديدا محتملا. ففي الوقت الذي لم يُسجل فيه أي انتقال للفيروس بين البشر حتى الآن، أثار الخبراء المخاوف بعد ظهور حالات إصابة بشرية في 10 ولايات أمريكية، ناتجة عن الاتصال بالدواجن أو الماشية المصابة، أو استهلاك الحليب غير المبستر. وعلى الرغم من أن الفيروس لا ينتقل من إنسان لآخر، فإن كل إصابة جديدة بين البشر أو الحيوانات تزيد من خطر تحوّر الفيروس ليصبح أكثر قدرة على الانتقال بين البشر.
وأوضح الدكتور كونور ميهان، الأستاذ في جامعة نوتنغهام ترينت، أن “الزيادة في الحالات هي مؤشر على خطر متزايد”.
وأضاف: “في حال حدوث تحور واحد في جينوم الفيروس، قد يصبح H5N1 قادرا على الانتقال بسهولة بين البشر، ما قد يؤدي إلى جائحة”.
وفي تطور جديد هذا الأسبوع، أعلنت الولايات المتحدة عن أول حالة إصابة بشرية شديدة بفيروس H5N1 في لويزيانا وكاليفورنيا. حيث تم تشخيص 36 حالة من إنفلونزا الطيور في البلاد، ما دفع السلطات للإعلان عن حالة الطوارئ بسبب الفيروس.
ولم تكشف السلطات بعد عن تفاصيل دقيقة حول حالة المصابين، باستثناء أنهم يعانون من أعراض شديدة بعد التعامل مع طيور مريضة ونافقة.
وعلى الرغم من أن الفيروس لا ينتقل حاليا بين البشر، أظهرت دراسات حديثة أن H5N1 قادر على التحور ليصيب الثدييات بشكل أفضل. ففي وقت سابق من هذا الشهر، اكتشف علماء في معهد سكريبس للأبحاث أن طفرة جينية واحدة في الفيروس قد تسمح له بالتحول من إصابة خلايا الطيور إلى إصابة الخلايا البشرية في الجهاز التنفسي العلوي. وقال الدكتور إيان ويلسون، الباحث في المعهد: “كانت هذه الطفرة الوحيدة كافية لتغيير طبيعة الفيروس وجعلها أكثر قدرة على الانتقال بين البشر”.
وتتزايد الاستعدادات لمكافحة فيروس H5N1 في مختلف الدول. فقد قامت المملكة المتحدة بشراء 5 ملايين جرعة من لقاح H5N1، في حين كانت فنلندا أول دولة تقدم لقاحات ضد إنفلونزا الطيور للبشر في يونيو الماضي، حيث تم تطعيم 10000 شخص من العاملين الذين تعرضوا للحيوانات. كما قامت الحكومة الأمريكية بالتعاون مع شركة موديرنا لتطوير لقاح mRNA خاص بإنفلونزا الطيور.
ويحذر الخبراء من تزايد خطر تأثير الفيروس على صحة الحيوانات في المستقبل القريب. ووفقا للدكتور ميهان، من المرجح أن يتسبب فيروس H5N1 في أضرار كبيرة لصحة الحيوانات في عام 2025، حتى إذا لم يتمكن من الانتقال بين البشر.
وأكد على أن “الفهم المبكر للأمراض المعدية في بيئتنا والحيوانات من حولنا سيساعدنا في الاستعداد بشكل أفضل لمكافحة هذه الأمراض قبل أن تنتقل إلى البشر”.
المصدر: ديلي ميل
 منبر العراق الحر منبر العراق الحر
منبر العراق الحر منبر العراق الحر